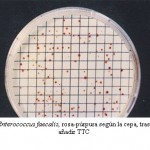
SLANETZ SIN ttc

Enterococos fecales SLANETZ-BARTLEY AGAR , medio ISO 7899 para detección y recuento de Enterococos fecales en aguas
Selección de enterococos fecales por filtración de membrana (ISO 7899-2:2001, UNE 77-076:1991, BOE 45 de 21/2/2003 de aguas de consumo humano, BOE 259 de 29/X/2003 de aguas de bebida envasadas).
COMPOSICIÓN
- Triptosa 20,00 g
- Extracto de levadura 5,00 g
- Glucosa 2,00 g
- Hidrog.Fosfato di-K 4,00 g
- Azida sódica (Na N3) 0,40 g
- Agar-agar 12,00 g
- (Fórmula por litro)
- pH final: 7,2 ± 0,2
PREPARACIÓN
Disolver 43.5 g de medio en 1 litro de agua bidestilada. Calentar, agitando, hasta ebullición para su total homogeneización y dejar 5 minutos más en agua hirviendo. Evitar el excesivo calentamiento y enfriar rápidamente. No autoclavar. Una vez enfriado a 50-60°C, añadir 10 ml de una solución de TTC al 1% (MICROKIT SDA018). El color final del medio es incoloro-paja. Este medio sustituye al Slanetz-Bartley completo, sin tener que preocuparse de los eventuales sobrecalentamientos que vuelven de color rosa a éste.
PARA USO EXCLUSIVO EN LABORATORIO. AGITE EL BOTE ANTES DE USAR. MANTENGA EL BOTE BIEN CERRADO EN LUGAR SECO, FRESCO Y OSCURO.
DESHIDRATADO CODIGO: DMT117
CONTROL DE CALIDAD DEL MEDIO
Realizado en nuestro laboratorio; es prudente repetirlo en su laboratorio siempre que varíen las condiciones (más de 3 meses sin usar, tras desinfectar laboratorio, tras conservar a alta Tª, cuando adquiere aspectos extraños aunque no haya llegado la fecha de caducidad teórica de la etiqueta,…)
DESHIDRATADO: Polvo fino, Amarillo PREPARADO: Estéril, Crema
CONTROL DE CRECIMIENTO CUANTITATIVO 48 h a 37°C aprox.:
E.coli MKTA 25922, Inhibido.
Bacillus subtilisMKTA 6633, Inhibido.
Enterococcus duransMKTA 10541, Bueno, Colonias rosas-granates, pequeñas. Con respecto a TSA estandarizado*, recuento 120-133%, pero de forma selectiva.
Enterococcus faecalis MKTA 29212, Bueno, Colonias rosas-granates, pequeñas. Con respecto a PCA estandarizado*, recuento 111-270%, pero de forma selectiva.
* El que cumple con recuperación superior al 92-125% con respecto a cepas cuantitativas trazables a la cepa tipo. Incertidumbres detectadas entre todos los lotes a lo largo de un año (la mayoría de la incertidumbre se debe a la cepa y a la proporción de cepas acompañantes inoculadas, no al medio).
PRESENTACIÓN: MEDIO DESHIDRATADO. NUEVO: PLAQUIS ® PREPARADAS HERMÉTICAS PARA M.F. con TTC: Ref. PPL909
En caldo preparado con TTC: Viales 2 ml, Viales Pinchables 100 ml.
Medio selectivo indicado para aislamiento y recuento de estreptococos fecales en agua y en alimentos, con la técnica de filtración de membrana o con el método de siembra en superficie.
SIEMBRA.
Sembrar en superficie 0.1 ml de muestra y extender con asa de Digralsky, o bien la membrana filtrada. Incubar a 36 ºC aproximadamente, 44 horas (para mejor selectividad, a 44-45 ºC aproximadamente, preferiblemente tras 4h a 36°C aproximadamente).
INTERPRETACIÓN.
Las colonias rojas, rosas o castañas, elevadas y diminutas se consideran presuntivas de estreptococos fecales del subgrupo de los Enterococos. El color rojizo es menos intenso cuanto más viejo es el medio. Deben confirmarse resembrándolas en Agar Bilis Esculina Azida (MICROKIT DMT160), donde crecen con halo tostado-negro en sólo 2 horas adicionales. Resembrando la membrana, se confirma el 100% de las colonias. Tambien es diferencial la prueba rápida del PYR (KWD103).
Si desea más información sobre nuestro MEDIO SLANETZ BARTLEY BASE, rellene nuestro formulario de contacto http://www.medioscultivo.com/contacto . O si lo prefiere póngase en contacto con nosotros a través de nuestro correo electrónico microkit@microkit.es o por teléfono en el nº 91-897 46 16
https://www.microkit.es/fichas/SLANETZ-BARTLEY-AGAR-BASE-SIN-TTC.pdf
Si necesita mayor rapidez, consulte estos otros dos medios para siembra directa en ellos:
https://www.microkit.es/fichas/BILE-ESCULIN-AZIDE-AGAR.pdf
https://www.microkit.es/fichas/CROMOKIT-ENTEROCOCCUS-AGAR.pdf
https://www.microkit.es/monograficos/16-Enterococos-fecales-monograf–a.pdf

